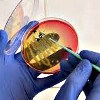

Запись
500₽
+7(383 ..показать +7(499) 11-68-239+7(383) 312-01-22
Клиника Медпрактика на Красина Новосибирск; ул. Красина, д. 68 ; м. Березовая роща
Запись
550₽
+7(383 ..показать +7(499) 11-68-239+7(383) 388-73-24
Клиника XXI век на Выборной Новосибирск; ул. Выборная, д. 89/2 ; м. Золотая нива
Запись
550₽
+7(383 ..показать +7(499) 11-68-239+7(383) 388-73-24
Клиника XXI век на Некрасова Новосибирск; ул. Некрасова, д. 35 ; м. Сибирская
Запись
605₽
+7(495 ..показать +7(499) 11-68-239+7(495) 945-79-82 +7(495) 653-14-57
Мединцентр во 2-ом Боткинском проезде Москва; 2-ой Боткинский проезд, д. 5, корп. 5 ; м. Беговая
Запись
650₽
+7(383 ..показать +7(499) 11-68-239+7(383) 332-05-51
Медсанчасть №168 на Арбузова 1/1 Новосибирск; ул. Арбузова, д. 1/1, корп. 4 ; м. Студенческая
Запись
660₽
+7(996 ..показать +7(499) 11-68-239+7(996) 051-26-36 +7(861) 212-52-88
ЭкспрессМедСервис на Ставропольской Краснодар; ул. Ставропольская, д. 96/1 ;
Запись
700₽
+7(495 ..показать +7(499) 11-68-239+7(495) 023-60-84
МЕДСИ на Рублевском шоссе Москва; Рублёвское шоссе, д. 10 ; м. Кунцевская
Запись
700₽
+7(495 ..показать +7(499) 11-68-239+7(495) 023-60-84
МЕДСИ на Ленинском проспекте Москва; Ленинский пр-т, д. 20, стр. 1 ; м. Шаболовская
Запись
800₽
+7(383 ..показать +7(499) 11-68-239+7(383) 304-84-11 +7(913) 933-96-78 +7(383) 209-04-62
Клиника Диагност в Горском микрорайоне Новосибирск; Горский мкр, д. 8 ; м. Студенческая
Запись
800₽
+7(495 ..показать +7(499) 11-68-239+7(495) 150-45-85
Доктор Озон на Старокачаловской Москва; ул. Старокачаловская, д. 6 ; м. Бульвар Дмитрия Донского
Запись
920₽
+7(383 ..показать +7(499) 11-68-239+7(383) 303-03-03
Клиника Пасман на Блюхера Новосибирск; ул. Блюхера, д. 71/1 ; м. Студенческая
Запись
920₽
+7(383 ..показать +7(499) 11-68-239+7(383) 303-03-03
Клиника Пасман на Карамзина Новосибирск; ул. Карамзина, д. 92 ; м. Маршала Покрышкина
Запись
990₽
+7(495 ..показать +7(499) 11-68-239+7(495) 363-03-63 +7(800) 200-36-30
ИНВИТРО в 1-м Кожуховском проезде Москва; 1-й Кожуховский проезд, д. 9 ; м. Автозаводская
Запись
990₽
+7(495 ..показать +7(499) 11-68-239+7(495) 363-03-63 +7(800) 200-36-30
ИНВИТРО на Хорошевском шоссе Москва; Хорошевское шоссе, д. 22 ; м. Беговая
Запись
1095₽
+7(499 ..показать +7(499) 11-68-239+7(499) 705-75-25
Клиника доктора Есиповой в Шмитовском проезде Москва; Шмитовский пр-д, д. 16, стр. 2 ; м. Выставочная
Запись
1100₽
+7(495 ..показать +7(499) 11-68-239+7(495) 781-60-06 +7(495) 781-70-07
Евромедсервис в 4-м Верхнем Михайловском проезде 4-й Верхний Михайловский пр-д; д. 10, корп. 6 ;
Запись
1400₽
+7(499 ..показать +7(499) 11-68-239
Клиника Евроонко на Межевом Канале Санкт-Петербург; Межевой канал, д. 4А ; м. Нарвская
Запись
1500₽
+7(495 ..показать +7(499) 11-68-239+7(495) 255-30-11
Евромедпрестиж на Донской Москва; ул. Донская, д. 28 ; м. Шаболовская
Запись
3749₽
+7(495 ..показать +7(499) 11-68-239+7(495) 781-55-77 +7(800) 302-55-77 +7(495) 104-86-05 +7(800) 775-42-74
GMS Hospital на Каланчевской Москва; ул. Каланчевская, д. 45 ; м. Комсомольская
Запись
990₽
+7(800 ..показать +7(499) 11-68-239+7(800) 200-36-30 +7(495) 363-03-63
ИНВИТРО на Волгоградском проспекте Москва; Волгоградский пр-т, д. 51 ; м. Текстильщики
Ещё клиник - 388 . Используйте фильтры